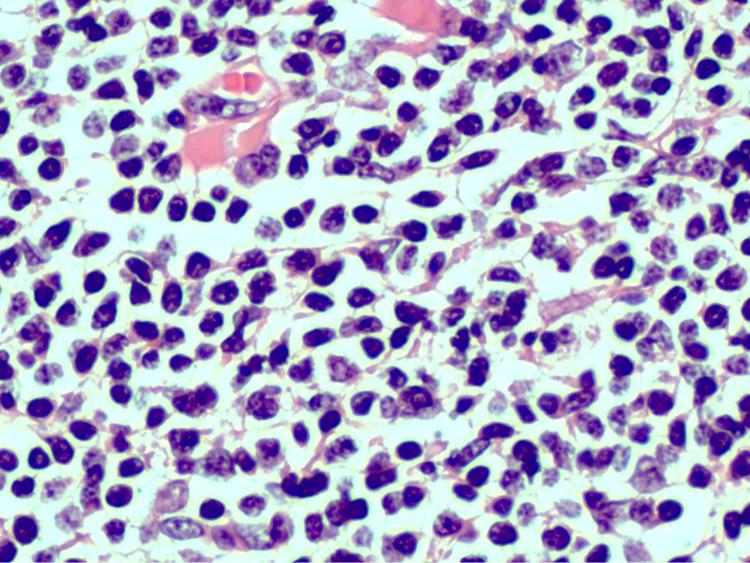
https://cdn.ncbi.nlm.nih.gov/pmc/blobs/22bc/8216313/0dd0192f9c3f/cureus-0013-00000015172-i03.jpg

累及肾脏和肾盂的黏膜相关淋巴组织淋巴瘤
Mucosa-Associated Lymphoid Tissue Lymphoma Involving the Kidney and Renal Pelvis.
作者信息
Gromicho Alexandre, Araújo Débora, Oliveira Vítor, Ribeiro Ana, Ferraz Luís
机构信息
Urology Department, Hospital Central Funchal, Funchal, PRT.
Urology Department, Centro Hospitalar Vila Nova de Gaia/Espinho EPE, Vila Nova de Gaia, PRT.
出版信息
Cureus. 2021 May 22;13(5):e15172. doi: 10.7759/cureus.15172.
Mucosa-associated lymphoid tissue (MALT) lymphomas are a distinctive group of B-cell lymphomas. These lymphomas arise from various anatomic sites and are mainly seen in the gastrointestinal tract, but the primary involvement of the kidney is extremely rare. We report a case of a MALT lymphoma involving the kidney and the renal pelvis. A 56-year-old man presented with a history of hematuria and left flank pain. A computed tomography scan showed a marked tissue densification in the renal sinus, suggesting marked thickening of the urothelium, conditioning deformity of the renal pelvis and calyces. A cystoscopy confirmed a 2-cm papillary lesion on the left lateral aspect of the bladder. The patient underwent laparoscopic radical nephoureterectomy and transurethral bladder resection. The pathological diagnosis was MALT lymphoma in the kidney and urothelial carcinoma of the bladder. The patient was referred to a hematologist and was free of disease at 20 months of follow up without additional treatment.
黏膜相关淋巴组织(MALT)淋巴瘤是一组独特的B细胞淋巴瘤。这些淋巴瘤起源于各种解剖部位,主要见于胃肠道,但肾脏原发性受累极为罕见。我们报告一例累及肾脏和肾盂的MALT淋巴瘤病例。一名56岁男性,有血尿和左侧腰痛病史。计算机断层扫描显示肾窦组织明显致密,提示尿路上皮明显增厚,导致肾盂和肾盏畸形。膀胱镜检查证实膀胱左侧有一个2厘米的乳头状病变。患者接受了腹腔镜根治性肾输尿管切除术和经尿道膀胱切除术。病理诊断为肾脏MALT淋巴瘤和膀胱尿路上皮癌。患者转诊至血液科医生处,随访20个月时未接受额外治疗,无疾病复发。